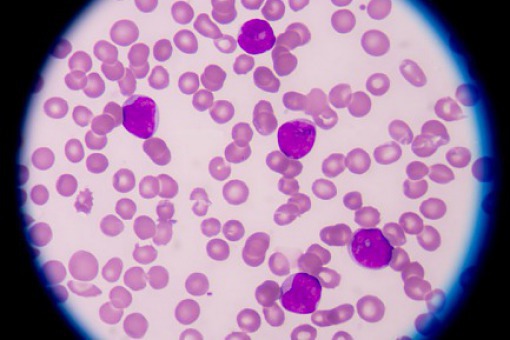

02.12.2021
Redaktor:
Arleta Czarnik
Leki hamujące aktywację dopełniacza to przełom w leczeniu mikroangiopatii zakrzepowej
Do niedawna nie było dostępne żadne skuteczne leczenie mikroangiopatii zakrzepowej – ciężkiego powikłania przeszczepu hematopoetycznych komórek macierzystych związanego z wysoką śmiertelnością. Wprowadzenie terapii skierowanej przeciwko składowej C5 dopełniacza przyniosło przełomową poprawę przeżycia pacjentów.
Mikroangiopatia zakrzepowa związana z przeszczepem (transplant-associated thrombotic microangiopathy – TA-TMA), która jest ciężkim i dość częstym powikłaniem przeszczepu hematopoetycznych komórek macierzystych (hematopoietic stem cell transplantation – HSCT) u dzieci, istotnie wpływa na przeżycie całkowite. Śmiertelność jest bardzo wysoka, w ciężkich przypadkach z zespołem dysfunkcji wielonarządowej (multi-organ dysfunction syndrome – MODS) sięga 90%. Główną rolę w patogenezie odgrywa uszkodzenie śródbłonka, a kluczowym czynnikiem jest nadmierna aktywacja dopełniacza skutkująca wysokim stężeniem C5b-9 w osoczu. Obraz kliniczny stanowi połączenie nieimmunologicznej niedokrwistości hemolitycznej, małopłytkowości i uszkodzenia narządów (nerek, skóry, serca, płuc, wątroby, jelit, ośrodkowego układu nerwowego).
Diagnoza oparta na kryteriach laboratoryjnych jest trudna, ponieważ nakładają się na siebie objawy innych powikłań HSCT: choroby przeszczep przeciwko gospodarzowi, infekcji i toksyczności leków. TA-TMA występuje w ciągu pierwszych 100 dni po HSCT, zazwyczaj pod koniec 1. i 2. miesiąca po przeszczepie, niezależnie od wieku i płci dawcy oraz biorcy, częściej w alogenicznym niż w autologicznym HSCT.
Do niedawna nie było dostępne żadne skuteczne leczenie. Dopiero w ostatnich latach wprowadzono leki hamujące aktywację dopełniacza. Stosowanie humanizowanego przeciwciała blokującego składową C5 – ekulizumabu – przyniosło przełomową poprawę rocznego przeżycia po przeszczepie w grupie wysokiego ryzyka TA-TMA, które zwiększyło się z 17% do 64%. W Polsce ekulizumab został po raz pierwszy z powodzeniem podany 19-letniej pacjentce z TA-TMA po HSCT z powodu ostrej białaczki szpikowej na oddziale autora. Poprawę osiągnięto już po jednej dawce, a trzy dawki przyniosły remisję niedokrwistości, małopłytkowości, ostrego uszkodzenia nerek zależnego od dializy i ciężkich zmian skórnych.
W celu uzyskania optymalnych wyników terapia powinna być modyfikowana zgodnie z parametrami farmakokinetycznymi i farmakodynamicznymi. Inne leki ukierunkowane na dopełniacz, m.in. rawulizumab, są obecnie w fazie testów.
Pełna treść artykułu: Tomasz Jarmoliński. Transplant-associated thrombotic microangiopathy. Pediatr Pol 2021; 96 (3): 207-212.
Diagnoza oparta na kryteriach laboratoryjnych jest trudna, ponieważ nakładają się na siebie objawy innych powikłań HSCT: choroby przeszczep przeciwko gospodarzowi, infekcji i toksyczności leków. TA-TMA występuje w ciągu pierwszych 100 dni po HSCT, zazwyczaj pod koniec 1. i 2. miesiąca po przeszczepie, niezależnie od wieku i płci dawcy oraz biorcy, częściej w alogenicznym niż w autologicznym HSCT.
Do niedawna nie było dostępne żadne skuteczne leczenie. Dopiero w ostatnich latach wprowadzono leki hamujące aktywację dopełniacza. Stosowanie humanizowanego przeciwciała blokującego składową C5 – ekulizumabu – przyniosło przełomową poprawę rocznego przeżycia po przeszczepie w grupie wysokiego ryzyka TA-TMA, które zwiększyło się z 17% do 64%. W Polsce ekulizumab został po raz pierwszy z powodzeniem podany 19-letniej pacjentce z TA-TMA po HSCT z powodu ostrej białaczki szpikowej na oddziale autora. Poprawę osiągnięto już po jednej dawce, a trzy dawki przyniosły remisję niedokrwistości, małopłytkowości, ostrego uszkodzenia nerek zależnego od dializy i ciężkich zmian skórnych.
W celu uzyskania optymalnych wyników terapia powinna być modyfikowana zgodnie z parametrami farmakokinetycznymi i farmakodynamicznymi. Inne leki ukierunkowane na dopełniacz, m.in. rawulizumab, są obecnie w fazie testów.
Pełna treść artykułu: Tomasz Jarmoliński. Transplant-associated thrombotic microangiopathy. Pediatr Pol 2021; 96 (3): 207-212.



